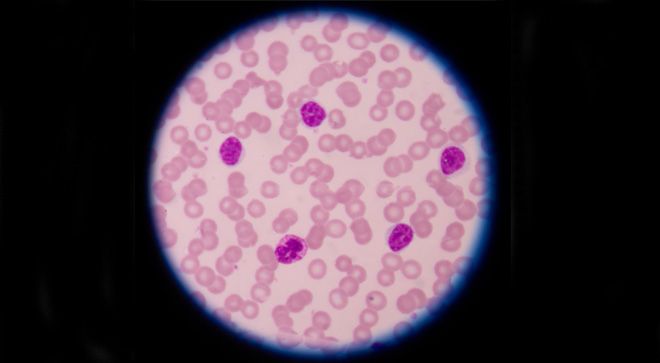

CLL
Latest News
Latest Videos
More News

The Bruton tyrosine kinase inhibitor showed a statistically-significant and clinically-meaningful improvement in progression-free survival in patients with previously-treated CLL.

Most people have heard the term "new normal" for individuals living, surviving and struggling with cancer. What actually does that mean?

Risk for disease progression among patients with chronic lymphocytic leukemia over time differed between those with mutated or unmutated disease, showing that gene somatic hypermutation plays a role throughout the disease course.

An expert discusses new treatment options for patients diagnosed with CLL.

Patients with relapsed or refractory chronic lymphocytic leukemia may have more options now than ever before, according to William G. Wierda, M.D., Ph.D.

While novel agents continue to evolve in the treatment landscape for chronic lymphocytic leukemia, many may start to be combined in the front-line setting as well, according to Matthew S. Davids, M.D., MMSc.
Time-limited treatment could be the new wave of research in the treatment of chronic lymphocytic leukemia (CLL), according to Nicole Lamanna, M.D.

Here are the top 5 CURE stories for February 2019.

A CLL diagnosis comes with new challenges, from understanding signs and symptoms and what the different stages mean.

Understanding CLL as a chronic disease.

Knowing treatment options and the possibilities of supportive care.

Utilizing clinical trials and understanding potential side effects and complications.

Finding follow-up care and emotional support.

Serving as a caregiver for a loved one going through a CLL diagnosis and treatment while utilizing resources to take care of oneself.

A list of helpful resources to assist people with CLL and their families cope with the emotional and practical aspects of the disease.

Imbruvica (ibrutinib) may be superior to standard of care in elderly patients with untreated chronic lymphocytic leukemia (CLL), according to phase 3 findings published in the New England Journal of Medicine.

Ian W. Flinn, M.D., Ph.D., discusses the use of Copiktra, which was approved in September for patients with relapsed/refractory chronic lymphocytic leukemia.

The Food and Drug Administration approved Imbruvica plus Gazyva for treatment-naïve patients with chronic lymphocytic leukemia/small lymphocytic lymphoma (CLL/SLL).

In this week’s episode of CURE Talks Cancer, we spoke with two doctors honored for their efforts to improve the quality of life for those affected by chronic lymphocytic leukemia (CLL).

Will the word "cure" be used for patients with chronic lymphocytic leukemia (CLL)?

Brian Koffman is a family physician who used his own CLL diagnosis to start a group that informs other patients and their loved ones.












